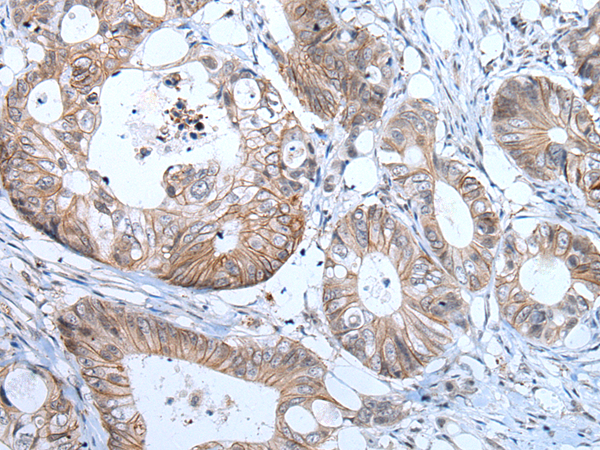
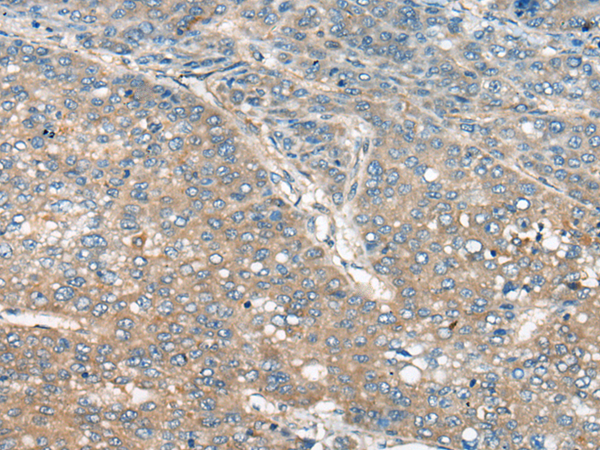

-
分类: 科研抗体货号: P06078别名: CT20; TSP50应用: IHC反应种属: Human
-
分类: 科研抗体货号: P06077别名: ARFL1应用: WB,IHC反应种属: Human, Mouse, Rat
-
分类: 科研抗体货号: P06123别名: RCN3; MCIP3; hRCN3; DSCR1L2应用: WB反应种属: Human, Mouse
-
分类: 科研抗体货号: P06075别名: BXDC1; bA397G5.4应用: WB,IHC反应种属: Human
-
分类: 科研抗体货号: P06188别名: ALC1; CHDL应用: IHC反应种属: Human, Mouse
-
分类: 科研抗体货号: P06121别名: CAIN; PPP3IN; KB-318B8.7应用: IHC反应种属: Human, Rat
-
分类: 科研抗体货号: P06074别名: CELF-5; BRUNOL5; BRUNOL-5应用: WB反应种属: Human
-
分类: 科研抗体货号: P06175别名: ME2; FMI2; CDHF9; HFMI2; ADGRC1应用: IHC反应种属: Human
-
分类: 科研抗体货号: P06119别名: EA5; EJM; CAB4; EIG9; EJM4; EJM6; CACNLB4应用: WB反应种属: Human, Mouse, Rat
-
分类: 科研抗体货号: P06073别名: CELF-4; BRUNOL4应用: IHC反应种属: Human, Mouse

鄂公网安备42018502007531号
鄂公网安备42018502007531号

